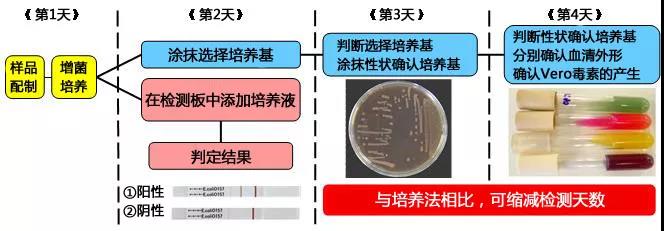

NH免疫层析系列”是通过免疫层析法检测能引起食物中毒细菌的试剂盒。通过与传统的培养法相结合,能减少检测时间、节约检测成本。
◆检测项目
● 肠出血性大肠杆菌O157
● 肠出血性大肠杆菌O26
● 肠出血性大肠杆菌O111
● 肠出血性大肠杆菌O103
● 李斯特菌
● 沙门氏菌
● 弯曲杆菌
● Vero细胞毒素(VT1、VT2)
◆产品特点
● 成本低
产品价格是市面现售免疫层析试剂盒中最便宜的。与培养法相比,可减少包含人工费用在内的检测成本。
● 操作简单
仅需在检测条上滴下增菌液。
● 简单快速地判定检测结果
检测开始15分钟后,只需确认紫红色线即可判定检测结果。与培养法相比,操作简单,检测时间短。
● 产品丰富
大肠杆菌O157产品已取得国际认证机关AOAC-PTM认证。
大肠杆菌O26、O111、O10用简易检测试剂盒是世界首发的试剂盒。
Vero毒素检测试剂盒,可分别检测VT1和VT2。
本品检测法与培养法的比较(大肠杆菌O157
O111检测法(能与O157同时进行检测)
在依据公定法对肠出血性大肠杆菌O157进行检测时,从样品配制到获得各种结果,需要花费4天时间。但采用免疫层析法检测的话,仅仅需要2天时间(※)
另外,只需要追加O111检测条,就能利用检测O157的样品,同时检测O111。
NH免疫层析法简便操作就能在短时间内得到检测结果,且适合用于筛选检测。
※ 免疫层析法检测出阳性结果时,需要用其它方法对其再进行确认。

Vero毒素(VT1、VT2)检测(使用#302-93321 NH免疫层析VT1/2)

②-1:检测开始15分钟后,可以分别在VT1检测线、VT2检测线和参照线位置观察到紫红色线时,可判定VT1和VT2均为阳性。
②-2:检测开始15分钟后,在VT2检测线和参照线位置观察到紫红色线时,判定为VT2阳性。
②-3:检测开始15分钟后,在VT1检测线和参照检测线位置观察到紫红色线是,判定为VT1阳性。
③:参照线位置观察不到紫红色线时,不管检测线是否出现,需再次进行检测。
◆产品列表
| 产品编号 | 产品名称 | 检测灵敏度 | 包装 |
| 304-31361 |
NH Immunochromato O157 NH免疫色谱出血性大肠杆菌0157 |
1×104~1×106CFU/mL | 20次用 |
| 304-34421 |
NH Immunochromato O26 NH免疫层析 O26 |
1×104~1×106CFU/mL | 20次用 |
| 301-34431 |
NH Immunochromato O111 NH免疫层析 O111 |
1×104~1×106CFU/mL | 20次用 |
| 382-03971 |
NH Immunochromato O103 NH 免疫色谱出血性大肠杆菌O103 |
1×104~1×106CFU/mL | 20次用 |
| 300-31581 |
NH Immunochromato Risteria NH免疫层析 李斯特菌 |
1×105~1×107CFU/mL | 20次用 |
| 303-31691 |
NH Immunochromato Salmonella NH免疫层析 沙门氏菌 |
1×105~1×107CFU/mL | 20次用 |
| 301-83141 |
NH Immunochromato Campylobacter NH免疫层析 弯曲菌 |
1×104~1×106CFU/mL 1×105~1×106CFU/mL |
20次用 |
| 302-93321 |
NH Immunochromato VT1/2 NH免疫层析 VT1/2 |
2.5ng/mL | 20次用 |
※ 仅供实验使用,不可用于临床诊断。